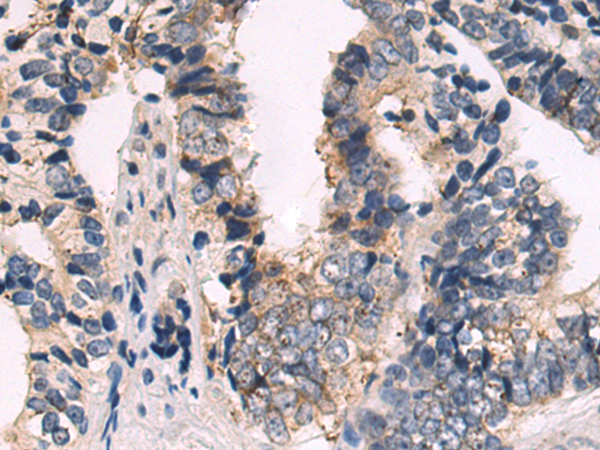

询价单号 点击跳转查看 X

| 编 号 | 规格 | 库存 | 目录价(¥) | 您的价格(¥) | 数 量 |
| D120495-0025 | 25 ul | 现货 | 500 | 500 | |
| D120495-0100 | 100 ul | 现货 | 1600 | 1600 | |
| D120495-0200 | 200 ul | 现货 | 2500 | 2500 |
概述
This gene is a member of the connexin gene family. The encoded protein is a component of gap junctions, which are composed of arrays of intercellular channels that provide a route for the diffusion of low molecular weight materials from cell to cell. Mutations in this gene may be associated with atrial fibrillation. Alternatively spliced transcript variants encoding the same isoform have been described.
应用
酶联免疫吸附测定(ELISA),免疫组织化学(IHC)
属性
| 保存缓冲液 | -20°C, pH7.4 PBS, 0.05% NaN3, 40% Glycerol |
| 运输条件 | 2-8°C |
| 靶点 Uniprot 登记号 | P36382 |
| 靶点基因 ID | 2702 |
| 靶点全称 | gap junction protein alpha 5 |
| 靶点别名 | CX40; ATFB11 |
| 靶点研究领域 | Signal Transduction, Cardiovascular |
| 亚型 | Immunogen-specific rabbit IgG |























 精确搜索
精确搜索 我的草稿
我的草稿
 我的购物车
我的购物车

 精确搜索
精确搜索




